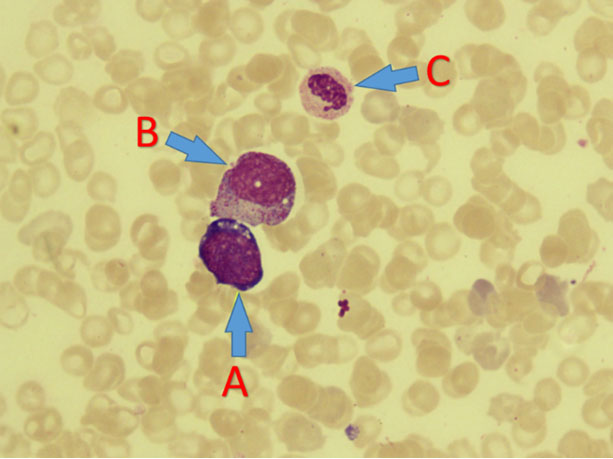

|
Case Report
Venous thromboembolism in children: A rare case report
1 Registrar, Department of Paediatrics, Lautoka Hospital, Lautoka, Fiji
2 MD, Paediatrics, MPhil (HHSM), Professor, Department of Paediatrics, College of Medicine, Nursing and Health Sciences, Fiji National University, Suva, Fiji
Address correspondence to:
Ashnita Ashvini Krishna
Department of Paediatrics, Lautoka Hospital, Lautoka,
Fiji
Message to Corresponding Author
Article ID: 101054Z01AK2019
Access full text article on other devices

Access PDF of article on other devices

How to cite this article
Krishna AA, Dubey AK. Venous thromboembolism in children: A rare case report. Int J Case Rep Images 2019;10:101054Z01AK2019.ABSTRACT
Introduction: Venous thromboembolism (VTE) is an uncommon presentation in the pediatric population. Although its incidence is 60 times less in children compared to adults, VTE is gaining increased importance due to the difficulty in investigating its cause, lack of evidence-based established treatment guidelines, and increased morbidity and mortality.
Case Report: This is a case report of a 3-year-old child who was being treated for pneumonia and was noticed to have diffuse edema on right chest wall and right upper extremity. Doppler ultrasound confirmed thrombosis of right subclavian and internal jugular veins. The patient was treated with anticoagulants but succumbed before the actual cause of VTE could be found. Bone marrow biopsy results obtained five days later showed findings suggestive of myelodysplastic syndrome (MDS) versus reactive causes such as systemic lupus erythematosus (SLE) and human immunodeficiency virus (HIV).
Conclusion: This case has been reported for the rarity of the condition, the many difficulties faced in working up to reach a diagnosis and the absence of standardized guidelines for treatment in children compared to adults.
Keywords: Anticoagulant therapy, Pediatrics, Venous thromboembolism
Introduction
Venous thromboembolism (VTE) is relatively uncommon in the pediatric population. The annual incidence of VTE in children is 0.07–0.14 per 10,000 children, or 5.3 per 10,000 hospital admissions of children, and 24 per 10,000 admissions to neonatal intensive care units (ICUs) [1] compared to 8.8 per 10,000 in adults [2]. Although the incidence of VTE is remarkably lower in children compared to adults, pediatric VTE is gaining increasing importance because of the difficulty in investigating its cause, lack of validated methods of treatment, and the severity of disease leading to serious morbidity and mortality.
We report a case of VTE for its rarity and highlight the challenges in investigating, diagnosing, and treating this patient.
Case Report
A 3-year-old Fijian of Indian descent previously well female presented with fever, shortness of breath, and bilateral periorbital puffiness for three days. There was no other remarkable past history of any significant illness. The child was born to non-consanguineous parents after an uneventful antenatal period. Birth, nutritional, developmental history were all unremarkable. Immunizations was up-to-date. There was no significant family history. Initially assessed as clinical nephrotic versus nephritic syndrome however this was ruled out by urine examination and absence of hypoalbunemia and hyperlipidemia. She was diagnosed as a case of pneumonia clinically and radiologically, and was being treated with crystalline penicillin and gentamicin. On day four of admission she developed swelling of her right eyes, upper and lower limbs that progressively increased over the next day to involve neck, shoulder, and chest wall on the right side. Given the clinical suspicion of vascular occlusion a right upper limb Doppler study was done which showed jugular vein thrombosis with no definite vascular flow within. Subclavian vein was also completely thrombosed and incompressible. The patient was immediately transferred to ICU and commenced on heparin infusion.
Examination revealed weight of 14 kg on admission but she gained more as her edema progressed specially on the right (Figure 1). The patient developed bilateral pleural effusion necessitating ventilation. She also developed ascites. Liver was palpable four finger breadths below the right costal margin, smooth, and non-tender. Genitalia was normal but right labia (Figure 2) was massively swollen by day 14 of admission. Fluid was oozing from all procedural sites.
Initial investigation profile showed hemoglobin (Hb) of 8.5 g/dL with microcytosis and hypochromia. Some atypical lymphocytes and increased platelets were noted. Blood culture grew Staphylococcus aureus sensitive to penicillin. Erythrocyte sedimentation rate (ESR) using the Westergrens method was normal (20 mm/h). Reticulocytes were 7.9%. Hepatitis and venereal disease research laboratory (VDRL) serology were negative. Pleural aspirate had red cells with 1600 white blood cells/mm3 which reduced to 320 white blood cells/mm3 on a repeat tap five days later. Biochemistry analysis [glucose 6.7 mmol, total protein 1 g/L, albumin 18, lactate dehydrogenase (LDH) 234 U/L] showed effusion was transudative in nature. No malignant cells seen. Culture was negative and no acid-fast bacilli (AFB) were seen. Ascitic fluid also had red blood cells and 160 white cells/ mm3, cultures were negative, glucose 6.7 mmol, total protein 19 g/L, Alb 10.2 g/L, LDH 234 U/L. The serum ascites albumin gradient was >1.1 g/dL indicating portal hypertension, negative for malignant cells. Her liver functions deteriorated over the course of admission. Antinuclear antibodies (ANA) and double stranded DNA (DsDNA) done to rule out SLE were also negative. Computed tomography (CT) scan revealed multifocal segments of venous thrombosis involving right internal jugular vein (Figure 3), left brachiocephalic, main portal vein, superior mesenteric, and hepatic veins. There was no obvious neck thoracic or abdominopelvic mass. Moderate ascites were with bilateral pleural effusion. Liver showed inhomogeneous enhancements/nutmeg liver with thrombosis of hepatic veins (Figure 4). Liver biopsy was contemplated, however poor general condition and deranged coagulation profile precluded the invasive procedure.
Troponin was normal. Echo study was also normal. Uric acid (UA) 616 umol/L and LDH 3498 U/L were extremely elevated which lead to the clinical suspicion of lymphoreticular malignancy mainly Burkitt’s lymphoma (BL) as a cause of the thrombosis. Burkitt’s lymphomas are known to present either by obstruction of the structures with lumen like blood vessels, bones, compression of structures, infiltration, or by tumor lysis with LDH and urate rise. In view of systemic vein thrombosis and picture of tumor lysis, possibility of lymphoreticular malignancy and autoimmune disorder were entertained. Vanillylmandelic acid (VMA) estimation was requisitioned to rule out an occult neuroblastoma, however, could not be done for want of facility. Protein C, protein S, and antithrombin III deficiency and factor V Leiden and prothrombin gene mutation could not be determined for the same reason. Bone marrow aspirate was done after 14 days of investigations and while awaiting official reports the patient was started on hyperhydration 125 mL/BSA/h and methylprednisolone.
The patient continued to deteriorate each day with no success in finding the cause of thrombosis. Warfarin was commenced along with heparin on the second day of heparin itself, coagulation profile was monitored and on day nine heparin was ceased. Warfarin continued to maintain international normalized ratio (INR) within 2–3.
The patient succumbed on day 17 of admission without answers to her illness. The bone marrow biopsy result (Figure 5) and (Figure 6) obtained five days after the loss of patient was suggestive of hematological malignancy like MDS versus autoimmune disorders like HIV/SLE.
Discussion
The incidence of VTE in children is low, due to them having protective mechanisms, e.g., deficiency of coagulation factors leading to decreased generation of thrombin, increased capacity of α2-macroglobulin to inhibit thrombin, enhanced antithrombotic potential of vessel wall, and children not being exposed to thrombotic predictors like smoking and antiphospholipid antibodies (aPL) [3].
Among the many causes of thromboembolism (TE) in children, central venous catheter is the most important acquired trigger contributing to more than 90% of neonatal venous thrombosis and more than 50% of all cases in other age groups [4],[5]. More than 90% of children with VTE have ≥2 predisposing factors [6]. Other risk factors include malignancy, infection, trauma, surgery, congenital heart disease, and lupus. Congenital prothrombotic conditions include factor V Leiden mutation (G1691A), prothrombin gene mutation, and deficiencies of antithrombin III (G20210A), protein C, and protein S.
Acute lymphoblastic leukemia (ALL) is the most common cancer associated with thrombosis in children with rates varying from 1.1% to 36.7% and an average of 3.2% [7].
In one retrospective study of 726 children with cancer, the risk of TE was highest with ALL, followed by sarcoma and lymphoma, and the lowest risk was seen in children with brain tumors [8]. Data based on small studies estimate that the prevalence of TE is 11% in children with acute myeloid leukemia (AML) and 12% in those with lymphoma [9],[10]. The clinical suspicion of BL was high in this patient as serum LDH and UA were high. Burkitt’s lymphoma typically presents with rapidly growing tumor masses and has very high serum LDH and elevated UA levels. Burkitt’s lymphoma comprises 30% of pediatric lymphomas [11]. Bone marrow was not suggestive of malignancy but of MDS versus autoimmune disorders like SLE/HIV. This patient could well be having HIV, one test that was missed in our investigation while in search for more complicated diseases. Systemic lupus erythematosus was ruled out. The evidence for VTE in pediatric patients with MDS is lacking. Adult studies state that the cause of death in MDS patients is usually related to the consequences of the leukemic evolution or to clinical events outside leukemia, such as cardiac failure, infection, hemorrhage, and hepatic cirrhosis [12]. Myelodysplastic syndrome patients have a low baseline risk of thrombosis due to the high frequency of thrombocytopenia and severe anemia. The vascular risk seems to increase significantly when chemotherapeutic drugs, such as thalidomide or lenalidomide, are used in association with erythropoiesis stimulating agents, which do not seem to increase the thrombotic risk when used alone [13]. Whether this patient was a true case of MDS or not is still a question in our minds given the lack of data.
Human immunodeficiency virus infection has also been recognized as a prothrombotic condition and is associated with a two- to tenfold increased risk of venous thrombosis in comparison with a general population of the same age. Studies on pediatric HIV versus VTE are not available. In general, VTE frequency among HIV infected patients ranges from 0.19% to 7.63%/year [14]. Abnormalities leading to hypercoagulable state such as presence of aPL and the lupus anticoagulant; deficiencies of protein C, protein S, heparin cofactor II, and antithrombin; and increased levels of von Willebrand factor and D dimers have been reported in patients with HIV who had thrombotic disease. These abnormalities correlate with the severity of HIV-associated immunosuppression as measured by CD4+ cell counts. Several studies confirmed that there is a higher incidence of venous thrombosis in patients with low CD4 counts [15],[16], however, the exact mechanisms by which this phenomenon occurs is unclear. Although the frequency of VTE is higher in the presence of lower CD4+ cell counts, there are reports of thrombosis occurring with CD4+ cell counts as high as 800 cells/mm3, suggesting that the risk of thrombosis is not completely confined to patients with end-stage disease [14]. Advanced HIV disease and opportunistic infections is a risk factor for thrombosis [17],[18]. Venous thromboembolism is most common with cytomegalovirus and Pneumcystis jirovecii pneumonia (PCP) and Mycobacterium avium-intracellulare [19],[20]. In fact, P. jirovecii pneumonia patients with HIV have been shown to have a high rate of concurrent antiphospholipid syndrome that may increase the risk for developing VTE [21].
Pediatric patients with SLE and aPL, specifically lupus anticoagulants (LAC) are at high risk of developing TE [22]. According to some authors, thrombotic events are the first complications of SLE after reactivation (“flares”) of the disease and infections [23]. A study by Levy et al. reviewed data on 149 pediatric SLE patients treated over 10 years. In all, 24 patients (16%) were LAC positive, and 21 TE occurred in 13 of these LAC positive patients (54% incidence of TE in LAC positive patients). Systemic lupus erythematosus, however, was ruled out in our patient.
For the diagnosis of VTE, Doppler ultrasonography (USS), venography, CT, and magnetic resonance imaging (MRI) can be used. Venography is rarely used as it is invasive, painful, and difficult to access in children. Noninvasive Doppler USS should be the first modality to diagnose thrombosis in children, especially in lower extremities. Doppler USS may not detect thrombosis in upper extremities or pelvis in children [24]. Computed tomography with intravenous contrast is used to evaluate the upper venous system and abdominal and pelvic venous systems. Ventilation-perfusion radionucleotide lung scanning and helical or spiral CT or MRI angiography are used to diagnose pulmonary embolism. Magnetic resonance imaging and magnetic resonance angiography (MRA) are recommended to confirm the diagnosis of cerebrovascular occlusion, superior vena cava, and proximal subclavian veins. Echocardiography can detect cardiac and proximal superior vena cava thrombi [6].
The mainstay of treatment for pediatric VTE is anticoagulation. Recommendations for antithrombotic treatment are based on small-scale studies in children and most of the guidelines are adopted from adult protocols[3]. Unfractionated heparin (UFH) is mostly used for the initial treatment because of its short half-life [6]. Heparin acts by enhancing the activity of antithrombin. Low molecular weight heparin (LMWH) with anti-Xa activity can also be used and is preferred in the pediatric population as it can be administered subcutaneously and has lower risk of heparin-induced thrombocytopenia and osteoporosis [24]. Its pharmacokinetics are more predictable than UFH, thereby minimizing the frequency of monitoring. Low molecular weight heparin does not interfere with diet or drugs, a recurrent problem with oral anticoagulants [6]. However UFH is preferred in patients with risk of bleeding and compromised renal function [24]. The therapeutic range of UFH is 0.3–0.7 anti-Xa activity units/mL and LMWH is 0.5–1.0 anti-Xa activity units/mL [24], however, this is not how monitoring was carried out for this patient out of want of facility. Activated partial thromboplastin time (aPTT) was used. Obtaining samples for coagulation profile was also a challenge for us as the patient was very edematous. Vitamin K antagonists act through inhibition of vitamin K dependent, posttranslational carboxylation of coagulation factors II, VII, IX, and X [25]. The most commonly used agent is warfarin. The anticoagulant activity is measured by the prothrombin time (PT)/INR. Warfarin is, in general, not used in newborns and young infants because of the difficulty of keeping the patient in the therapeutic range. Newborns have physiologically low levels of vitamin K-dependent factors and variable intake of vitamin K (low in breast milk, high in formula, and the total parenteral infusions); the blood sampling for INR monitoring is often difficult and there is no liquid formulation for warfarin [25]. A new anticoagulant, argatroban is a direct thrombin inhibitor approved for pediatric use in the United States. It is given as a continuous intravenous infusion, and its anticoagulant activity is monitored with the aPTT, with a goal of aPTT of 1.5–3 times the normal [25], measured two hours after a steady intravenous (IV) infusion [26]. Argatroban has hepatic clearance, and thus should be used with caution in critical patients with hepatic dysfunction [25].
The recommended duration of heparinization during acute phase treatment is 5–10 days according to adult protocol [27]. Anticoagulation therapy can be extended in the subacute phase with LMWH or warfarin. International normalized ratio should be 2–3 in patients on warfarin therapy [27]. Anticoagulation therapy is recommended for 3–6 months for the first episode and 6–12 months for idiopathic VTE [27]. The use of thrombolytic agent such as recombinant tissue plasminogen activator (tPA) has also been suggested [8]. The goal of the thrombolysis is to relieve the vascular obstruction produced by the clot in a short period of time by activating the fibrinolytic system. It is used in life- or limb-threatening thrombosis, when time is of the essence. Tissue plasminogen activator may be administered systemically, or via a catheter, at the site of thrombosis [25]. In systemic thrombolysis it may be administered in doses of 0.1–0.6 mg/kg for six hours, as suggested in the American Association of Colleges of Pharmacy guidelines [28].
With increasing incidence of deep venous thrombosis (DVT) in the pediatric population, the issue of VTE prophylaxis in hospitalized children has gained increasing attention [25]. Venous thromboembolism prophylaxis combines physical as well as pharmacologic methods. Physical methods include sequential compression devices or compression stockings that reduce venostasis. Anticoagulants like LMWHs are used in doses half that used in VTE treatment, e.g., enoxaparin 0.5 mg/kg every 12 hours sq or 30–40 mg sq for larger, adult-sized adolescents [25].
The recurrence rate of VTE is approximately 3% of neonates, 8% in older children, and 21% of children with idiopathic VTE, and the mortality rate of pediatric pulmonary embolism is 2.2% [29].
The short-term complications are major hemorrhage due to thrombosis or secondary to anticoagulation and post-thrombotic syndrome characterized by edema, pain, skin pigmentation, and ulceration of affected limb.
Conclusion
This case has been reported for the rarity of the condition, the many difficulties faced in working up to reach a diagnosis and the absence of standardized guidelines for treatment in children compared to adults. Authors wish to raise the awareness of the practicing pediatricians about occurrence of VTE, the importance of ruling out of thrombophilic abnormalities, HIV testing that forms a sensitive issue as informed consent has to obtained, and as this can be the cause of potential VTE, physicians should not only be able to recognize and treat the well-known opportunistic infections and malignancies associated with this chronic disease, but also be alert to the less well-known complications such as thrombosis.
REFERENCES
1.
van Ommen CH, Heijboer H, Büller HR, Hirasing RA, Heijmans HS, Peters M. Venous thromboembolism in childhood: A prospective two-year registry in The Netherlands. J Pediatr 2001;139(5):676–81. [CrossRef]
[Pubmed]

2.
Little I, Vinogradova Y, Orton E, Kai J, Qureshi N. Venous thromboembolism in adults screened for sickle cell trait: A population-based cohort study with nested case-control analysis. BMJ Open 2017;7(3):e012665. [CrossRef]
[Pubmed]

3.
Spentzouris G, Scriven RJ, Lee TK, Labropoulos N. Pediatric venous thromboembolism in relation to adults. J Vasc Surg 2012;55(6):1785–93. [CrossRef]
[Pubmed]

4.
Andrew M, David M, Adams M, et al. Venous thromboembolic complications (VTE) in children: First analyses of the Canadian Registry of VTE. Blood 1994;83(5):1251–7.
[Pubmed]

5.
Schmidt B, Andrew M. Neonatal thrombosis: Report of a prospective Canadian and international registry. Pediatrics 1995;96(5 Pt 1):939–43.
[Pubmed]

6.
Parasuraman S, Goldhaber SZ. Venous thromboembolism in children. Circulation 2006;113(2):e12–6. [CrossRef]
[Pubmed]

7.
Athale UH, Chan AK. Thrombosis in children with acute lymphoblastic leukemia: Part I. Epidemiology of thrombosis in children with acute lymphoblastic leukemia. Thromb Res 2003;111(3):125–31. [CrossRef]
[Pubmed]

8.
Athale U, Siciliano S, Thabane L, et al. Epidemiology and clinical risk factors predisposing to thromboembolism in children with cancer. Pediatr Blood Cancer 2008;51(6):792–7. [CrossRef]
[Pubmed]

9.
Athale UH, Chan AK. Thromboembolic complications in pediatric hematologic malignancies. Semin Thromb Hemost 2007;33(4):416–26. [CrossRef]
[Pubmed]

10.
Athale UH, Nagel K, Khan AA, Chan AK. Thromboembolism in children with lymphoma. Thromb Res 2008;122(4):459–65. [CrossRef]
[Pubmed]

11.
Morton LM, Wang SS, Devesa SS, Hartge P, Weisenburger DD, Linet MS. Lymphoma incidence patterns by WHO subtype in the United States, 1992–2001. Blood 2006;107(1):265–76. [CrossRef]
[Pubmed]

12.
Cazzola M. Risk assessment in myelodysplastic syndromes and myelodysplastic/myeloproliferative neoplasms. Haematologica 2011;96(3):349–52. [CrossRef]
[Pubmed]

13.
Smith SW, Sato M, Gore SD, et al. Erythropoiesis-stimulating agents are not associated with increased risk of thrombosis in patients with myelodysplastic syndromes. Haematologica 2012;97(1):15–20. [CrossRef]
[Pubmed]

14.
Bibas M, Biava G, Antinori A. HIV-associated venous thromboembolism. Mediterr J Hematol Infect Dis 2011;3(1):e2011030. [CrossRef]
[Pubmed]

15.
Sullivan PS, Dworkin MS, Jones JL, Hooper WH. Epidemiology of thrombosis in HIV-infected individuals. The adult/adolescent spectrum of HIV diseases project. AIDS 2000;14(3):321–4. [CrossRef]
[Pubmed]

16.
Feffer SE, Fox RL, Orsen MM, Harjai KJ, Glatt AE. Thrombotic tendencies and correlation with clinical status in patients infected with HIV. South Med J 1995;88(11):1126–30. [CrossRef]
[Pubmed]

17.
Jenkins RE, Peters BS, Pinching AJ. Thromboembolic disease in AIDS is associated with cytomegalovirus disease. AIDS 1991;5(12):1540–2. [CrossRef]
[Pubmed]

18.
Saber AA, Aboolian A, LaRaja RD, Baron H, Hanna K. HIV/AIDS and the risk of deep vein thrombosis: A study of 45 patients with lower extremity involvement. Am Surg 2001;67(7):645–7.
[Pubmed]

19.
Baker JV, Neuhaus J, Duprez D, et al. Changes in inflammatory and coagulation biomarkers: A randomized comparison of immediate versus deferred antiretroviral therapy in patients with HIV infecton. J Acquir Immune Defic Syndr 2011;56(1):36–43. [CrossRef]
[Pubmed]

20.
Abgueguen P, Delbos V, Chennebault JM, Payan C, Pichard E. Vascular thrombosis and acute cytomegalovirus infection in immunocompetent patients: Report of 2 cases and literature review. Clin Infect Dis 2003;36(11):E134–9. [CrossRef]
[Pubmed]

21.
Wagner KR, Chaisson RE. Pulmonary complications of HIV infection. In: Wormser GP, editor. AIDS and Other Manifestations HIV Infection. 4ed. USA: Elsevier; 2004. p. 407–21. [CrossRef]

22.
Levy DM, Massicotte MP, Harvey E, Hebert D, Silverman ED. Thromboembolism in paediatric lupus patients. Lupus 2003;12(10):741–6. [CrossRef]
[Pubmed]

23.
Bertoli AM, Alarcón GS, Calvo-Alén J, Fernández M, Vilá LM, Reveille JD. Systemic lupus erythematosus in a multiethnic US cohort: Clinical features, course, and outcome in patients with late-onset disease. Arthritis Rheum 2006;54(5):1580–7. [CrossRef]
[Pubmed]

24.
Jung HL. Venous thromboembolism in children and adolescents. Blood Res 2016;51(3):149–51. [CrossRef]
[Pubmed]

25.
Radulescu VC. Management of venous thrombosis in the pediatric patient. Pediatric Health Med Ther 2015;6:111–9. [CrossRef]
[Pubmed]

26.
Young G, Boshkov LK, Sullivan JE, et al. Argatroban therapy in pediatric patients requiring nonheparin anticoagulation: An open-label, safety, efficacy, and pharmacokinetic study. Pediatr Blood Cancer 2011;56(7):1103–9. [CrossRef]
[Pubmed]

27.
28.
Monagle P, Chan AKC, Goldenberg NA, et al. Antithrombotic therapy in neonates and children: Antithrombotic therapy and prevention of thrombosis, 9th ed: American college of chest physicians evidence-based clinical practice guidelines. Chest 2012;141(2 Suppl):e737S–801. [CrossRef]
[Pubmed]

29.
Wright JM, Watts RG. Venous thromboembolism in pediatric patients: Epidemiologic data from a Pediatric tertiary care centre in Alabama. J Pediatr Hematol Oncol 2011;33(4):261–4. [CrossRef]
[Pubmed]

SUPPORTING INFORMATION
Acknowledgments
The authors would like to thank Dr Virisila Ciri for histopathological confirmation of the diagnosis and Dr Krishneel Krishna for helping in typing and computer work.
Author ContributionsAshnita Ashvini Krishna - Conception of the work, Design of the work, Acquisition of data, Analysis of data, Drafting the work, Revising the work critically for important intellectual content, Final approval of the version to be published, Agree to be accountable for all aspects of the work in ensuring that questions related to the accuracy or integrity of any part of the work are appropriately investigated and resolved.
Alok Kumar Dubey - Conception of the work, Design of the work, Revising the work critically for important intellectual content, Final approval of the version to be published, Agree to be accountable for all aspects of the work in ensuring that questions related to the accuracy or integrity of any part of the work are appropriately investigated and resolved.
Guarantor of SubmissionThe corresponding author is the guarantor of submission.
Source of SupportNone
Consent StatementWritten informed consent was obtained from the patient for publication of this article.
Data AvailabilityAll relevant data are within the paper and its Supporting Information files.
Conflict of InterestAuthors declare no conflict of interest.
Copyright© 2019 Ashnita Ashvini Krishna et al. This article is distributed under the terms of Creative Commons Attribution License which permits unrestricted use, distribution and reproduction in any medium provided the original author(s) and original publisher are properly credited. Please see the copyright policy on the journal website for more information.